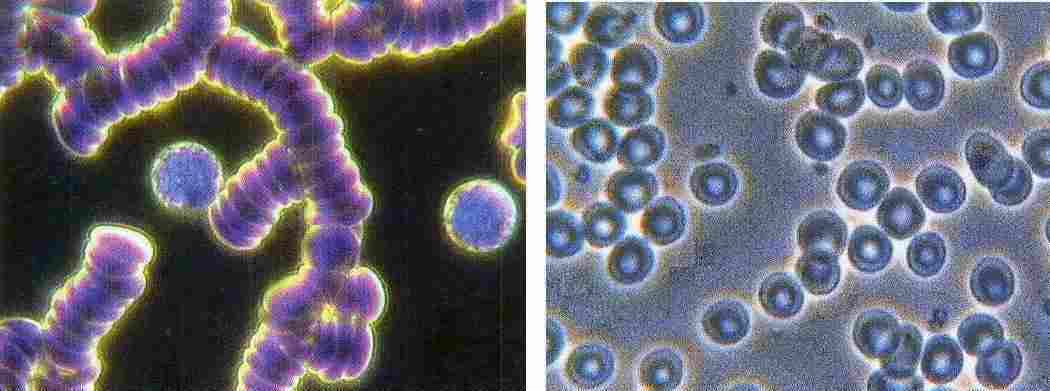

|
The
Aqua - meaning Water
Chi - meaning Energy
Aqua
Water is the most abundant substance on earth and is the principal
constituent of all living things.
Since ancient times, people have bathed in water from mineral springs,
especially hot springs, because of its supposed therapeutic value for
rheumatism, arthritis, skin diseases, and various other ailments. Many
such springs have become sites for health spas and resorts. Some of the
most famous are: Bath, Avon, England, Baden-Baden and Wiesbaden, Germany,
Saratoga Springs, New York, and Hot Springs National Park, Arkansas. For
the diseased and convalescent, many spas offer medical therapy. For all
persons, the spa has been and continues to be, in a variety of ways, a
place of healing. So the benefits of naturally charged water have been
known for centuries.
Chi
Traditional Chinese Medicine embraces the profoundly elegant concept of
internal energy, "Chi" (variant spelling, "Ki", or "Qi"), or "Vital Life
Force". Chi is also called, "breath". It is regarded as a vital force
present in the breath of bodily fluids. Chi energy or live force
circulates freely through a healthy body, but levels of Chi (energy) can
become low in an unhealthy body by way of stress, causing illness and
toxin build-up in the body. When the Chi energy begins to flow strongly
and unobstructed in the body, the body begins to unwind and strengthens
itself, better coping with today's environmental pressures.
Aqua-Chi
So, Aqua-Chi is like bathing in your own naturally charged hot spring at
home. It essentially rebalances and amplifies the body's bio-electric
signature (since the body is 80% water, and it uses water as its
conductor, and charges the body's battery. The best way to find out if
Aqua-Chi is for you is to try it and feel the difference! Aqua-Chi can
affect each individual differently, as each individual is a little
different. So the effects of Aqua-Chi can vary from person to person.
AQUA-CHI HYDRO
STIMULATION SYSTEM
The process that uses Hydro Stimulation
to help the body detox naturally.
EXPERIENCE YOUR BODY RELEASING TOXINS
The Aqua-Chi
Hydro Stimulation System is a state-of-the-art "bio-energy charger"
which raises health care to a new level. It energizes water the most
abundant resource on earth, with direct current (DC) to create an energy
field which research has shown is bio-available to living things.
The Aqua-chi
Hydro Stimulation System re-balances and amplifies your body’s
bioelectric field enabling the body to heal itself. It's like recharging
you body’s battery. A reason why people don’t heal is because they run
out of energy.
Water is the essence of life! Nothing on this planet can exist without
this vital substance, so doesn't it make sense that water being the
source of all life is also the carrier of this same life-force! The Aqua
Chi uses water to transfer ENERGY!
Water has an
almost perfect balance of positive and negative ions. The positively
charged ions are hydrogen ions (H+) and negatively charged ions are
hydroxide ions (OH-).
The AQUA-CHI System is based on a technology that has been available
since 1996. Water is used as the Biological base and with the Water
Module (Biological Transceiver) immersed in the water we can enjoy the
Energy of a Natural Hot Spring Bath or Foot Bath.
The frequency
from the Aqua-Chi Hydro Stimulation System enhances the ionic transfer
on a cellular level in the whole body, increasing the function ability
of the organs, maintaining health, preventing dis-eases.
Modern day
living exposes us human beings to an excess of pollutants and various
toxins in the air we breathe, the food we eat and the water we drink.
Most of these toxins get deposited in the various cells in the body
especially adipose (fat) tissues, blood cells, brain, heart, liver,
kidney and other tissues. Toxins get trapped in those cells causing
malfunction of those cells tissues and organs, leading to various
symptoms such as: tiredness, fatigue, headaches, aging of the skin,
eczema, pain in the muscles, joints and many others, the list goes on
and on…
The body
eliminates the toxins physiologically mainly though the major 5
elimination channels: Lungs, Kidneys, Liver, Skin and Colon. The use of
the Aqua-Chi Hydro Stimulation System has been proven with various lab
tests including, Live blood microscopy, Volls method of screening and
others that the function of the cells are stimulated and enhanced
through the use of the Aqua-Chi Hydro Stimulation System.
Lipolysis is
one of the mechanisms the body uses to get rid of fat and adipose
tissues by burning the fat in the body, once the fat cell is destroyed
the toxins are released, collected by the blood and the lymphatic system
and eliminated through the major 5 elimination organs, the Aqua-Chi
Hydro Stimulation System enhances lipolysis thus helping in releasing
the toxins, burning the fat under the skin, and in the whole body thus
the skin will breath & look better. Enhancing Lipolysis will also aid in
weight control.
We believe the order of events in getting well first starts with the
body’s bioelectric field, (our body’s all have different vibratory
rates), the second is oxygen (studies have shown the Aqua-chi System
improves oxygen levels) and the third is nutrition and food.
When there is
an imbalance, there is more likely to be dis-ease within the body. A
balanced Bioelectric field is important as is a good level of Oxygen and
Nutrients to enable the body dispose of waste products (toxins) in the
normal way. Less Toxins equals a healthy body, a healthy body has
greater ability to heal naturally.
The AQUA-CHI
Hydro Stimulation System is self contained and is used in an ordinary
bath or foot bath and helps increase Body Energy, Vitality, Natural
Healing, Detoxifies and balances the Electrical body. We have seen very
positive and encouraging results when the Aqua-Chi has been used in the
treatment of: Allergies, Asthma, Arthritis, General Pains, Heavy Metal
Toxins, Detoxification, Rapid Healing, Muscular injuries, Menstrual
Problems, Menopausal Problems, Headaches, Toothaches, Improved
Concentration, Increased Perception, Improved Liver and Kidney Function,
Deeper Improved Sleep, Reduced Fluid Retention, Reduced Swelling,
Cramping, Some Skin Conditions, Helps Open Detoxification Pathways.
One of the most visual effects of the Aqua-Chi Hydro Stimulation System
is the release of Toxins and Oils trapped in the dermal layers (Skin),
after an Aqua-Chi bath treatment the skin has a very smooth feeling.
When the electric body is balanced Detox Pathways are also more
efficient.
Water Module (Biological Transceiver):
Sometimes call an Antenna because of its ability to transmit and receive
a signal. The Module consists of a series of rings, which is powered by
a DC current power supply unit. The materials used to build the module
are of precise dimensions and ratios every detail is crucial to the
effectiveness of the field produced and the quality of the life force
enhancement produced.
Questions & Answers
• 1 Describe
how the system draws toxins from the body:
The
aqua chi Hydro-Stimulation system can only help to withdraw toxins. As
massage or exercise, It enhances lipolysis ( destruction of fat cells,
where toxins are mainly stored ), There is improvement in the function
of all the cells in the body including the 5 major elimination
channels: Lungs, Kidneys, Liver, Skin and Colon. Thus enhancing the
physiological De-tox mechanism in the body. Toxins will be released
for few days after the use of the machine, which has been proven with
blood & urine tests.
• 2 Why is the withdrawal of
these toxins beneficial to clients?
Living beings are amazingly complex in the way they function in the
battle to survive whether that was a plant, an animal or a human
being, if full of toxins a plant will die, humans may become ill.
Toxins are continuously being eliminated naturally, but some times
especially in our century where we are exposed to various chemicals
from pesticides to air, water & other pollutants, any help is
important no matter how minute it is.
It is important for the vitality of our cells to be free of toxins,
thus maintaining healthy body &
mind.
• 3 How many
sessions does a client need to undertake before results become
visible?
Although the
results cannot be always replicated in every case, we have been having
repeatedly very good results in various cases, where pains are
disappearing, energy levels improving, quicker recovery from colds &
various other visible results which are sometimes noticeable from only
1 session. There is no magical cure for anything, it is important to
be patient & give any method the recommended time to achieve good
results.
We
advise a minimum of 2 sessions per week for 3 to 4 weeks and once
every 7 – 10 days thereafter.
•
4 Are there any contraindications that would make this treatment
unsuitable for some clients?
There are no contra-indications, but we recommend people wearing a
pacemaker, those that suffer from fits or seizures, have had an organ
transplant, are pregnant or nursing mother or those taking
prescription drugs should only be treated under the supervision of a
suitably qualified person.
• 5 What
treatments would you recommend salons link the Detox with? (For
example, pedicures or body wraps)
Our
aqua-Chi Hydro-Stimulation system is unique in a way that it’s made to
be used with foot spas or Jacuzzi. The skin has a very smooth and
clean feeling after an Aqua-Chi treatment especially when used in the
bath. So the effect of body wraps after an aqua chi session will be
improved.
• 6
How simple is it to introduce the system to the salon? (For example,
plumbing or space requirements)
Very
easy just needs space for a chair and footbath and needs to be close
to a power point.
• 7 What
makes the Detox system an attractive salon service? (For
example, increased profits or client interest)
This is another
service to offer clients to achieve better results & also increases
saloon profitability.
• 8 What is
the waste matter left in the water once the treatment ends?
One
of the most visual effects of the Aqua-Chi Hydro Stimulation System is
the release of Toxins and Oils trapped in the dermal layers (Skin) &
from lipolysis, some of the waste will salt & minerals from the
transducers. The colour change is not the important issue here. The
body will keep eliminating toxins via the main elimination organs.
• 9 What do
different types of waste matter tell you about the client’s
health/well-being?
It
is not possible and we should not try to read anything into the
different colours of the waste matter. It differs with each person as
we all have a different energy frequency (bio-electric body) and when
the Aqua-Chi Stimulation System balances the bioelectric body the
Detox pathways can react in different ways. Urine & blood tests are
the way to determine the efficacy of any Detox process.
• 10 Cynics
claim Detox systems appear to work simply through a chemical reaction
brought about by the electric current running through salted-water,
and don’t actually draw toxins out of the body at all. How do you
respond to this?
The colour change of
the water is not the important issue here; However, a darker colour is
observed in people who take too many medications or have more serious
health problems or toxins. The frequency is passed to every single
cell in the body & not only the feet.
• 11 What
distinguishes your system from others on the market?
Aqua-Chi is
based on technology that has been available since 1996, producing a
frequency that enhances the ionic transfer on a cellular level in the
whole body, increasing the function ability of the organs, maintaining
health, preventing dis-eases. The aqua-Chi System can be safely used
as a
Footbath or Whole Body Bath.
Throughout the
session the, some of the salt in the water will be consumed by the
electrical current & depending on the skin resistively the therapeutic
frequency may change in some systems in the market, our system
automatically alters & regulates the current to maintain the same
frequency level.
Full back up
service available and the system is also covered by a 3 year extended
warranty. Certified Training is available from Dr. Succar’s School
“SCI-AN” , a BCMA registered school.
If you have
any further enquires, we will be happy to answer all your questions.
Testimonials
A customer came to use our Aqua Chi Machine. She had recently retired
because of severe arthritis in her hands. After one treatment She was
able to open and close both hands. She commented her pain was 80%
better. After five treatments, she had no more pain and 100% mobility
back. She then asked her husband to try the Aqua-Chi treatments. He
had Asthma and used oxygen at night and inhalers during the day. After
two treatments he stopped using the oxygen and night and after five
treatments was able to quit using the inhalers. He saw a remarkable
change in his ability to breathe.
Glen Ohmert, health food store owner
The Aqua-Chi Machine is working for me! I am continuing to respond
well to treatments, while only time will tell whether it will cure my
schleroderma it has certainly provided more relief that anything else
I've tried and healing is very apparent. I would not hesitate in
recommending it to other sufferers of this affiliation.
Wilbert Bentz
I have
experienced kidney failure and poor kidney function throughout my
life. I obtained an Aqua-Chi machine and had amazing results! Since
using the Aqua-Chi Machine I have not had kidney failure. I have been
a nurse for 18 years and tried to stay current on whatever could aid
my condition. It was this machine that led to my break through for a
healthier, happier existence. I believe that electromagnetic field
therapies such as the Aqua-Chi are way ahead of their time and that
this technology helps many disorders/diseases. I highly recommend that
folks try this out for themselves.
Sincerely, Lori Niell
Prior to my purchasing the Aqua-Chi Machine I had not had a menstrual
cycle in three months. I'm only 35 so I knew it couldn't be
peri-mentopause. After 5 treatments my menstrual cycle returned to
normal. I also noticed less cramping and a shorter cycle also had
increased energy and a better mental attitude.
Sincerely, K. Foster
I was
suffering from Candida overgrowth which was localized in my bladder
and uterus. This was the cause of my low energy. After receiving a
35-minute Aqua-Chi foot bath, I felt much stronger. The therapist and
I were shocked to find that the Candida seemed to have cleared out of
my bladder and uterus. She stated that she had never seen anyone's
energy field shift so dramatically in such a short period of time!
Since using the Aqua-Chi Machine on a regular basis, I have noticed
that I have more energy and stamina and that I sleep more soundly. I
also have to add that the technical support for the machine is great!
The makers really stand behind their product. I'd recommend that
everyone should have an Aqua-Chi Machine in his or her home!
Larisa McClung
I had
heard that the Aqua-Chi machine helped relieve muscular tension from
rigorous workouts. I purchased a machine and found this to be true. I
have also noticed the texture of my skin at the age of 51 seemed
softer and my wrinkles less prominent. My menopausal symptoms are
greatly reduced and I am sleeping through the night.
Sincerely, Tina Holl
I was
born with a defect at the base of my right kidney I had surgery after
nearly dying from kidney failure. All was well until I took a
homeopathic remedy of Silica as I'd forgotten about the shunt that was
put in my body. My body then began to reject this shunt and I started
to loose vitality and retain fluid. When I went in for a test they
found that the ureter had started to shrivel but my bladder was in
such bad shape they couldn't see how it held any fluid at all. Their
option for me was to see a neurologist and go on medication...not an
option I was willing to consider ! I then purchased the Aqua-Chi
Machine. after a few treatments I was able to hold my urine and my
vitality began to return. It has been interesting to see the color of
the water change and smell the chlorine leaving my body. I am an
organic farmer so I have been able to return to my chores again which
is a real blessing. I have recommended the Aqua-Chi to many of my
friends and they have all had as dramatic results as myself.
Amandah Jensan, B. C. Canada
|

 AQUA-CHI
MACHINE
AQUA-CHI
MACHINE